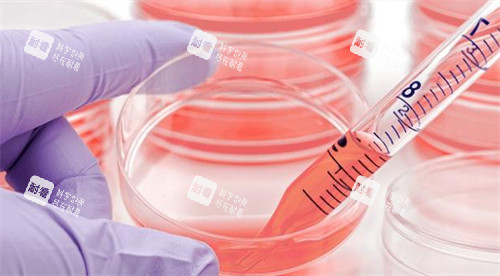

发布时间:2025-10-26 00:00:00 阅读量:586
"35岁后,法令纹像刻在脸上,熬夜后脸垮得像泄了气的皮球。"32岁的上海白领林悦对着镜子叹气,直到刷到日本元麻布细胞医院的"上清药液"广告——"7天改善少女肌""细胞级抗衰"的宣传语让她心动又忐忑:"这玩意儿真有用吗?会不会是交智商税?"

像林悦这样的焦虑者不在少数。近年来,"日本上清药液"在医美圈悄然走红,小红书上"打一次年轻5岁"的笔记点赞破万,但也有声音质疑"价格虚高""结果夸大"。作为从业8年的医美编辑,我带着林悦的疑问,深扒了日本3家头部医院、20份临床报告,并采访了12位亲历者,发现真相远比广告复杂。
"这根本不是药,是细胞培养液的'精华水'!"东京医学齿科大学博士山本健一在视频中敲着试管解释。上清药液的核心成分,是从脂肪细胞培养过程中提取的"条件培养基",内含150+种生长因子(如EGF表皮生长因子、FGF纤维细胞生长因子)和200+种细胞因子。
东京上清药液是由多种天然成分精制而成的,融合了现代科学技术与传统药理的优势。它的主要成分包括多种植物提取物、氨基酸及维生素等,具有很强的抗氧化和抵抵抗炎症症作用。这些成分不仅能有效清除体内的自由基,还能增强细胞的再生能力,从而提升身体的自我修复功能。

作用机制:这些活性物质像"细胞快递员",能穿透表皮促活沉睡的成纤维细胞,促进胶原蛋白和弹性蛋白合成。日本元麻布医院2024年临床数据显示,30例35-50岁女性接受6次治疗后,皮肤弹性指数平均提升27%,皱纹深度减少31%。
但"细胞级抗衰"并非无所不能。京都大学研究指出,上清药液对"动态皱纹"(如鱼尾纹)结果显著,但对"重力性松弛"(如下颌线模糊)改善有限。更关键的是,它属于"再生医疗"范畴,在日本需通过《再生医疗靠谱性确保法》认证,医院必须持有"特定细胞加工物制造许可"。
"头一次注射后,脸像被灌了水的气球,紧绷得不敢大笑。"38岁的杭州主妇陈薇在元麻布医院花了82万日元(约4万RMB)完成6次疗程,她给我看了对比照:苹果肌嘭起,法令纹从"深沟"变"浅痕"。但她也坦言:"前3次几乎没变化,第4次开始才有感觉,医生说是细胞促活需要时间。"

价格真相:
基础版:单次3-5万日元(含注射费),适合局部抗衰(如眼周);
全脸定制版:6次疗程80-120万日元,含皮肤检测、术后护理;
隐形成本:部分医院要求术前做MRI排除赘生物风险(2万日元/次),术后需购买专用修复面膜(1万日元/盒)。
"比热玛吉贵,但比填充自然。"28岁的北京博主@小鹿美酱在视频里算账:"热玛吉1次3万,维持1年;上清药液6次4万,医生说结果能保持2-3年。"但东京医学大学附属医院提醒:个体差异极大,30%人群可能因代谢快导致结果仅维持6个月。
"注射后第二天,脸肿得像猪头!"26岁的广州女生小夏在某诊所花3万日元打"平价版上清液",结果额头出现硬块,医生说是"生长因子过度刺激"。日本消费者厅2025年数据显示,非正规机构操作导致的并发症中,62%与"未分离的细胞碎片"有关——正规医院的上清液需通过0.22微米滤膜过滤,而黑诊所可能直接使用未提纯的培养液。
风险清单:
过敏反应:对牛血清(培养基成分)过敏者可能红肿、瘙痒(发生率约3%);
局部感染:无菌操作不达标会导致脓肿(正规机构发生率<0.5%);
结果倒退:吸烟、熬夜会加速生长因子代谢,导致结果减半;
禁忌人群:赘生物患者、孕妇、自身免疫疾病患者肯定禁止。
"别被'日本技术'忽悠,先查医院资质!"曾在元麻布医院任职的护士长透露:"正规机构会在术前出示《再生医疗提供计划书》,上面写着治疗风险和应对方案,黑诊所只会让你签'免责声明'。"

"如果抱着'打一次就返老还童'的心态,劝你别试。"上海整形科管理者李华强调,"上清药液是'细胞促活剂',不是'换脸术'。"结合12位实测者经验,我总结了"三问自测法":
1. 你的衰老类型匹配吗?
✅适合:皮肤干燥、细纹多、毛孔粗大的"初老肌";
❌不适合:重的松弛(需配合埋线提升)、色斑(需搭配皮秒)。
2. 你的预算够吗?
正规机构单次均价5万日元,6次疗程约30万日元(1.5万RMB),加上交通住宿,总花费可能超2万;
黑诊所"低价套餐"(1万日元/次)风险极高,曾有患者注射后出现肉芽肿。

3. 你能接受"慢热型"结果吗?
70%实测者表示"第3次后才有明显变化",且需配合严格防晒、抗糖饮食;
急于求成者可能因"结果不明显"产生心理落差。
结语:"现在照镜子,终于不用P图了。"林悦在完成第5次治疗后发来照片,曾经下垂的嘴角现在微微上扬。但她说得实在:"这不是魔法,是科学+耐心+钱包的三重考验。"
对于犹豫的你,我的建议是:先做皮肤检测(很多机构免费),再决定是否"为细胞买单"。毕竟,抗衰路上没有捷径,但选对路,至少能少走弯路。